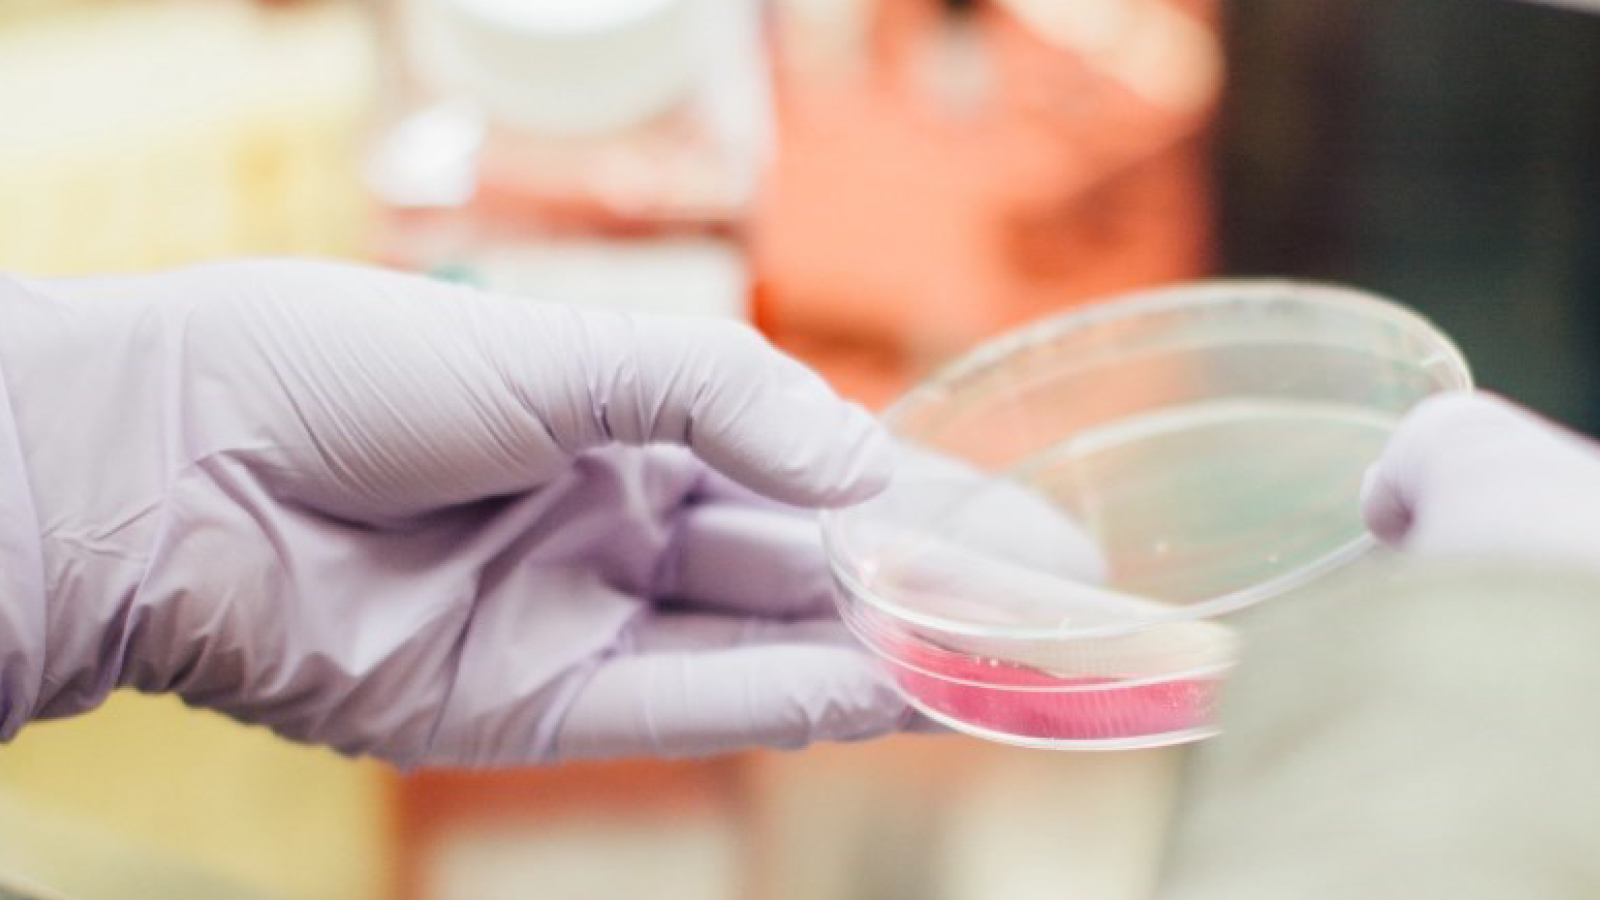

Science Resources for Middle and High School
Free activities, videos, and articles that make teaching science easier—and more fun!


This Free Air Quality Experiment Reveals Hidden Air Pollution at Your School


Free Flip-Book Lesson on the Stages of Mitosis


Free Acids and Bases Science Kit (Hands-On Experiment!)


80 Best High School Science Experiments and Projects for Every Subject


79 Best 8th Grade Science Fair Projects and Classroom Activities


50 Science Bell Ringers To Kick-Start Your High School Classroom


Free Printable Science Posters To Celebrate Black History All Year Long


NEW: Science by You
Get FREE activities and lessons created exclusively by real teachers like you, including new ideas and fresh takes on routine topics!

Biology
Explore engaging biology lessons, hands-on activities, and expert articles designed to make life science come alive in your classroom. From cell structure to ecosystems, you’ll find resources that help students understand key concepts, think critically, and connect biology to the world around them.

Free Photosynthesis Worksheets for Middle and High School
Five engaging printables including a maze, scavenger hunt, and diagram!

Biology Resources for Your Classroom
Fun lessons, standards-based kits, and more, all in one place!

How Do Living Things Work? 4 Classroom Activities
DNA, osmosis, diffusion, and photosynthesis hands-on activities.

Diffusion and Cell Size Lab
Discover how size impacts diffusion in this hands-on biology lab.

Gel Electrophoresis: Tools and Tips for Classroom Success
Make this complex technique simple and fun with this hands-on guide.

Microscope Power Pack
Take your class on an adventure into the unseen world.

Printable: Painted Lady Butterfly Activities
Observe and record butterfly life cycles and learn associated vocabulary.

Chemistry
Discover classroom-ready chemistry lessons, interactive activities, and expert articles that make abstract concepts tangible. From atoms and molecules to chemical reactions and lab safety, these resources help students explore the building blocks of matter while developing critical thinking and problem-solving skills.

Chemistry Resources for Your Classroom
Your chemistry classroom toolkit starts here—grab what you need!

15 Free Hands-On Chemistry Activities
From endothermic reactions to super-absorbent polymers.

Activity: The Periodic Table of Candy
Have students organize candies according to different properties.

5 Types of Chemical Reactions Class Demonstrations
Watch chemistry come alive with five exciting reaction demos your students will love!

Activity: Polyurethane Foam Reaction
Combine two liquids to create this fantastic reaction that will have your students in awe.

Periodic Table
Download this easily accessible periodic table that you can share with your students and put on display.

Geology & Earth Science
Bring the wonders of our planet into your classroom with lessons, activities, and articles that make Earth science engaging and accessible. From geology and weather patterns to natural resources and environmental systems, these resources help students explore how Earth works and why it matters.

Earth Science Resources for Your Classroom
From cool activities to standards-aligned kits, we’ve got your back!

Stream Table Power Pack
Four awesome tools to make geology and hydrology a splash in your classroom!

5 Fun Ways To Use Fossils in Your Classroom
Fossils can be used as evidence of tectonic plates and mass extinction!

The Best Earth Science Resources + Activities
Study photosynthesis and respiration with the help of homegrown algae.

From Peaks to pH: Water Science at the Top of the World
Explore water science at extreme altitudes with these Everest-inspired experiments.

Planetary Adventure Travel
Which planet in our solar system would be best for a NASA vacation resort? This fun lesson was created and written by classroom teachers.

Physics
Unlock the power of physics with lessons, activities, and articles that make abstract principles concrete and engaging. From motion and energy to forces and waves, these resources help students explore the laws that govern our universe while building problem-solving and analytical skills.

Physics Resources for Your Classroom
Standards-aligned lesson plans? Check. Fun? Check. Get it all right here!

Explore the Science of Color With These Awesome Articles
Receptors, wavelengths, color schemes, and more.

Activity: Newton’s Law Station
Activities written and created by classroom teachers to learn about inertia. Perfect for small groups!

Activity: Demonstrate Density Columns
Create a density column to put students in the thick of it.

Activity: Discover Exoplanets in a Galaxy Not So Near You
Simulate the Transit Method in a way that’s easy to grasp.

5 Troubleshooting Tips for Your Van de Graaff Generator
It’s perfect for teaching about electricity—but it can be finicky.

STEM
Fuel innovation and problem-solving with STEM resources that integrate science, technology, engineering, and math into engaging classroom experiences. Explore lessons, activities, and articles that inspire creativity, critical thinking, and real-world connections—helping students see how these disciplines work together to shape the future.

STEM Lessons and Activities
From fun lessons to standards-based kits, we’ve got it!

DIY Solar Cooker
Harness the power of the sun to cook your favorite treats.

Article: Hands-On STEM Made Easy
Get everything you need to make real-world connections.

7 Ways To Teach Robotics
Spark creativity and problem-solving with hands-on tech activities students can’t wait to try.

Activity: Design a Spacesuit in the Classroom
Spacesuits maintain body temperature in the extreme heat and cold of outer space.

Simple Machines and the Rube Goldberg Machine
Challenge students to design wild contraptions while mastering energy and motion concepts.

General Science
Find versatile lessons, activities, and articles that cover a wide range of science topics to support your middle and high school curriculum. These resources help students build foundational knowledge, explore scientific concepts, and develop critical thinking skills across multiple disciplines.

Keeping Science Class Exciting With These Kahoot! Quizzes
It’s no secret that Kahoot!s are the perfect way to reenergize a classroom. Check out these 12 Kahoot! games.

125 Science Trivia Facts for Kids and Teens
Spark students’ interest in and knowledge of science with this trivia.

Free Posters To Teach Students About the Scientific Method
Question, research, hypothesize, experiment, analyze, share.

Article: 24 Hands-On Science Kits for Middle and High School
Make hands-on learning easy with a ready-to-go kit.

Article: Surprising Science Careers To Share With Students
Get your students excited about a career in science!

Owl Pellet Reference Poster for Your Classroom
Add this colorful, bone-filled poster to your classroom and make owl pellet science unforgettable.

Free Science Poster Set
Download and print five posters for your classroom!

2026 Science-Themed Wall Calendar Download
Featuring captivating science-themed artwork and a clean, functional layout, this calendar is the perfect tool to stay organized all year long.

Monthly Science Activities
This special edition of the Ward’s World Science Activity Round-Up keeps students engaged throughout the year.

Lab Safety
Ensure a safe and successful science classroom with resources focused on lab safety best practices. From safety guidelines and checklists to engaging activities that teach proper procedures, these tools help you create a secure environment where students can experiment with confidence.

Chemical Safety in Your Lab: Dos and Don’ts
Keep your classroom safe and stress-free—discover the essential dos and don’ts for managing chemicals in your science lab.

A Quick Checklist for Lab Safety
This guide covers the keys to managing chemicals safely and efficiently in the classroom.

11 Things You May Not Know About Eye Protection
Think you know classroom eye safety? Discover surprising tips to keep every lab safe.
How To Find Safety Gloves That Fit Your Needs Like … Well, a Glove
Find the perfect gloves for every lab activity with this quick, easy guide.

How To Prepare a Scalpel and Stay Out of the ER
Master safe scalpel setup with this quick guide. Keep dissections sharp and stress-free.

Science Starts Here
Curiosity is the spark that ignites discovery—and we’re here to keep that spark burning bright. Ward’s Science offers hands-on resources and classroom-ready tools that make complex concepts come alive for middle and high school students. From engaging experiments to real-world applications, our materials help students think critically, ask big questions, and see science as an exciting journey rather than just a subject.
Explore our collection and bring the wonder of science into your classroom today!